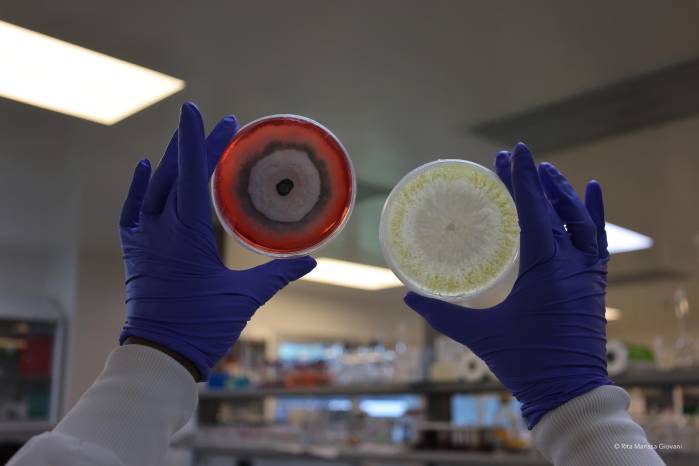
La investigación demuestra que es posible manejar el micobioma del cacao con hongos endófitos para mejorar su protección contra enfermedades como la moniliasis.

Integrantes de cuerpos de emergencia buscan víctimas este miércoles, luego de dos fuertes terremotos sacudieron el Caribe venezolano en Caracas (Venezuela)....

- 06/03/2026 00:00
Los hongos están en todas partes. Aunque muchas veces los asociamos con moho o enfermedades, lo cierto es que forman parte esencial de la vida en el planeta. Reciclan nutrientes en los bosques, hacen posibles alimentos como el pan y el chocolate, y producen medicamentos fundamentales como la penicilina. Su estudio, conocido como micología, ha cobrado más relevancia en la agricultura sostenible.
Esa importancia se pone de relieve con la publicación de un artículo científico en la revista Phytobiomes Journal en el que investigadores panameños reportan hallazgos sobre la relación entre hongos y cacao, el árbol del chocolate.
El estudio “The Interplay of Theobroma cacao Genetics and Its Pod Mycobiome on Controlling Pathogenic Fungus Moniliophthora roreri” fue desarrollado por un equipo coordinado por el fitopatólogo y micólogo Luis C. Mejía. Formó parte de la tesis doctoral del programa en Biociencias y Biotecnología de la Universidad Tecnológica de Panamá (UTP), de la Dra. Hilda Castillo, autora principal. También participaron los investigadores Yaleskia Valdés, Candelario Rodríguez, Enith I. Rojas y Marcelino Gutiérrez.
La investigación se centró en el árbol de cacao, Theobroma cacao, y en los hongos que viven dentro de sus frutos. Allí se encuentra uno de los enemigos del cacao en América Latina: la moniliasis, causada por el hongo Moniliophthora roreri, responsable de pérdidas económicas.
¿Qué descubrieron? “Descubrimos que las frutas de diferentes variedades genéticas de cacao albergan comunidades de hongos distintas en biodiversidad y composición”, explica la Dra. Hilda Castillo. “Vimos que algunos de estos hongos que viven naturalmente en la fruta pueden protegerla contra enfermedades como la moniliasis (Moniliophthora roreri), y que esta protección depende de la variedad genética de cacao. Además, encontramos que cuando estos hongos colonizan la fruta, también pueden inducir cambios en su química”.
El estudio demuestra que no todos los árboles de cacao son iguales, y que sus diferencias genéticas influyen en el tipo de comunidad de hongos que vive en sus frutos. Es decir, cada variedad tiene su propio “micobioma”.
El micobioma se refiere al “conjunto de todos los hongos que viven asociados a un organismo o parte de este, en este caso en los frutos del cacao”, detalla la Dra. Castillo. “Algunos conviven sin causar daño, y otros, incluso, ayudan a defender a la planta contra enfermedades. Prestar atención a este ‘universo invisible’ es clave porque puede marcar la diferencia entre un cultivo que pierde gran parte de su producción y otro que se mantiene sano”.
Uno de los aportes más relevantes del estudio es la propuesta de utilizar hongos endófitos como tratamiento biológico.
“Los hongos endófitos son microorganismos que viven de manera asintomática dentro de los tejidos de las plantas”, explica Mejía, investigador del Instituto de Investigaciones Científicas y Servicios de Alta Tecnología (Indicasat AIP) y del Instituto Smithsonian de Investigaciones Tropicales. “En lugar de ser enemigos, se convierten en aliados: algunos pueden competir con los hongos patógenos, producir sustancias que los inhiben o estimular las defensas naturales del cacao”.
Lo más interesante es que estos hongos ya están adaptados al ambiente interno del fruto. “Dado que las mazorcas permanecen en el árbol por hasta seis meses, contar con hongos aliados que colonicen su interior representa una protección continua en las etapas más críticas, cuando el patógeno de la moniliasis puede permanecer latente y es difícil de detectar o controlar en campo”, añade Mejía.
El tratamiento con estos endófitos también genera cambios químicos. “Nuestros ensayos se realizaron en frutos jóvenes a las 24 horas de la aplicación de endófitos, lo que captura la respuesta temprana de la planta a la colonización por endófitos”, aclara Castillo. “Los cambios observados reflejan una reprogramación metabólica inicial, pero no necesariamente el perfil final del fruto o grano maduro”.
Aun así, el hallazgo abre una puerta para futuras investigaciones sobre cómo estas modificaciones podrían influir en la calidad del cacao y, eventualmente, del chocolate.
Los investigadores consideran que estos hallazgos pueden contribuir al diseño de estrategias más eficientes para el control biológico de enfermedades vegetales y a un futuro con menos pesticidas sintéticos.
“El uso de hongos endófitos como aliados naturales ofrece varios beneficios. Para los agricultores, significa menores costos y menos riesgos de salud asociados a la aplicación de químicos. Para el ambiente, implica menos contaminación del suelo y del agua, y la preservación de insectos y microorganismos beneficiosos que suelen verse afectados por los pesticidas”, sostiene Mejía.
En un país como Panamá, donde se produce cacao orgánico y existe una demanda por chocolate libre de agroquímicos sintéticos, esta alternativa resulta relevante.
Reducir las pérdidas por moniliasis también tiene un impacto directo en la economía. “Para Panamá, esto significa que los agricultores pueden aprovechar mejor su cosecha y generar más ingresos. A nivel internacional, contribuye a asegurar una oferta más estable de cacao de calidad, lo que beneficia a toda la cadena de valor, desde pequeños productores hasta la industria chocolatera”, explica Castillo.
El artículo demuestra que Panamá está “generando aportes de relevancia internacional en un cultivo estratégico como el cacao”, afirma Mejía.
El proyecto también dejó una base científica importante. Con fondos de la Secretaría Nacional de Ciencia, Tecnología e Innovación (Senacyt) y del Banco de Microorganismos de Panamá (Biobanco Panamá), creado en el Indicasat AIP con respaldo del Ministerio de Ambiente, existe una colección de alrededor de mil cepas de hongos endófitos provenientes de frutos de cacao. De estas, 475 cepas fueron obtenidas con el proyecto y 141 se evaluaron por su bioactividad contra el patógeno de la moniliasis.
Este banco representa un punto de partida para desarrollar soluciones biológicas, coinciden.
El siguiente paso, señala Mejía, es ampliar las pruebas en campo y evaluar el efecto de estos hongos frente a otras enfermedades del cacao, como la escoba de bruja y la mazorca negra.
Además, el hallazgo podría transformar los programas de mejoramiento genético. Hasta ahora, estos programas se han enfocado en productividad y resistencia a enfermedades. El estudio propone incorporar una nueva dimensión: la relación entre el árbol y su micobioma.
“En el futuro, los programas de mejoramiento podrán integrar esta dimensión, seleccionando no solo árboles con buenas características, sino también aquellos que establezcan alianzas más efectivas con hongos protectores”, subraya Castillo.
Para el Dr. Mejía, quien ha publicado más de 50 artículos y lleva más de 25 años investigando hongos, la motivación sigue intacta. Desde que, siendo estudiante, quedó “enamorado de los hongos”, ha dedicado su carrera a comprender su importancia.
Su mensaje final es claro: “El mundo en que vivimos es altamente dependiente de los hongos”. Desde alimentos y bebidas hasta medicamentos y materiales innovadores, los hongos son fundamentales. “La investigación nos permite entender cuáles especies de hongos son clave para resolver problemas, y en el caso de microbiomas de plantas, nos está dando luces sobre cómo manejarlos para hacer a las plantas más resilientes a condiciones adversas y proteger cultivos de una manera alternativa al uso de plaguicidas sintéticos, lo que facilitará una producción agrícola más sostenible”.
En el interior de una mazorca de cacao, invisible al ojo humano, se libra una batalla microscópica. Gracias a la ciencia panameña, hoy sabemos que en esa batalla hay aliados naturales dispuestos a proteger el futuro del chocolate.











